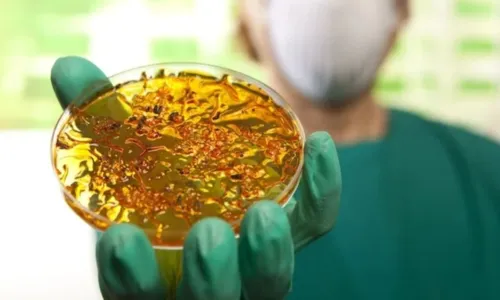
C�lera: saiba o que �, sintomas, transmiss�o e como se prevenir

Um novo caso de cólera foi registrado no Brasil após 18 anos. O paciente infectado é um idoso de 60 anos, residente de Salvador, sem viagens para fora do país.
Com o registro, as atenções da saúde voltam-se de novo para a doença, que já foi considerada uma epidemia no Brasil, no ano de 1991. Assim como, questionamentos começam a surgir: o que é a cólera? Quais os sintomas? Como é transmitida?
De acordo com o Ministério da Saúde, a cólera é uma doença bacteriana infecciosa intestinal aguda. Ela é transmitida por contaminação fecal-oral direta, ou pela ingestão de água, ou alimentos contaminados, e está diretamente ligada ao saneamento básico e à higiene.
A cólera é causada pela ação da toxina liberada por dois sorogrupos da bactéria Vibrio cholerar. Essa toxina se liga às paredes intestinais, alterando o fluxo de sódio e cloreto do organismo.
Por causa disso, o corpo começa a secretar grandes quantidades de água, o que provoca a diarreia aquosa, um dos principais sintomas da cólera, desidratação, perda de fluidos e sais mineiras.
Sintomas da cólera

Cólera é causada pela ação da toxina liberada por dois sorogrupos da bactéria Vibrio cholerar. Foto: Reprodução/Hospital São Luis
Segundo a nota técnica divulgada pela Secretaria da Saúde do Estado (Sesab), entre os sintomas da cólera estão:
- Diarreia líquida, de início súbito, com rápida e intensa desidratação
- Ainda pode ocorrer vômitos
O Ministério da Saúde inclui ainda dor abdominal e cãibras. Caso não seja tratada rapidamente, pode levar o paciente a graves complicações e até mesmo o óbito.
Formas de transmissão e período de incubação
A transmissão da cólera pode ocorrer de forma direta ou indireta, via fecal-oral. Na transmissão direta, a contaminação ocorre de pessoa para pessoa. Já na transmissão indireta, a cólera é passada a partir da ingestão de água ou alimentos contaminados durante a cadeira produtiva ou manipulação.
Além disso, como o agente causador da cólera faz parte do ambiente aquático, pode ser associado a mariscos, peixes, algas, entre outros, que possibilitem a transmissão da cólera caso esses alimentos sejam consumidos cruz ou mal cozidos.
O período de incubação de 2 a 3 dias, variando de 12 horas a 5 dias da exposição. Por questão de segurança, o Ministério da Saúde padronizou o período de 10 dias para incubação.
Transmissão da cólera pode ocorrer de forma direta ou indireta. Foto: Reprodução
Já para o tempo em que a bactéria pode ser transmitida, a vigilância foi padronizada para o período de transmissibilidade de 20 dias.
Como prevenir a cólera
- Lave sempre as mãos com sabão e água limpa, principalmente antes de preparar ou ingerir alimentos, após ir ao banheiro, após utilizar conduções públicas ou tocar superfícies que possam estar sujas, após tocar em animais, sempre que voltar da rua, antes e depois de amamentar e trocar fraldas;
- Lave e desinfecte as superfícies, utensílios e equipamentos usados na preparação de alimentos;
- Projeta os alimentos e as áreas da cozinha contra insetos, animais de estimação e outros animais (guarde os alimentos em recipientes fechados);
- Trate a água para consumo (após filtrar, ferver ou colocar duas gotas de solução de hipoclorito de sódio a 2,5% para cada litro de água, aguardar por 30 minutos antes de usar);
- Não utilize água de riachos, rios, cacimbas ou poços contaminados para banhar ou beber;
- Evite o consumo de alimentos crus ou mal cozidos (principalmente os frutos-do-mar) e alimentos cujas condições higiênicas, de preparo e acondicionamento, sejam precárias;
- Ensaque e mantenha a tampa do lixo sempre fechada; quando não houver coleta de lixo, este deve ser enterrado em local apropriado;
- Use sempre o vaso sanitário, mas se não for possível, enterre as fezes sempre longe dos cursos de água.
Fatores de risco da cólera
- Condições precárias de saneamento básico;
- Consumo de água sem tratamento adequado;
- Condições precárias de higiene pessoal;
- Consumo de alimentos sem higienização ou manipulação adequadas;
- Consumo de peixes e mariscos crus ou mal cozidos.
Complicações
As complicações da cólera ocorrem por causa do esgotamento do corpo, causado por diarreia e pelos vômitos. As complicações são mais frequentes em pessoas vulneráveis, como idosos, diabéticos, desnutridos, portadores do vírus HIV ou aqueles que tenham alguma patologia cardíaca prévia.
No caso de desidratação, caso não seja tratada de forma adequada, ela leva à deterioração progressiva de circulação, da função renal e do equilíbrio de água e minerais no corpo, causando dano a todos os sistemas do organismo.
- choque hipovolêmico (diminuição da quantidade de sangue circulante no corpo);
- necrose renal;
- fraqueza intestinal
- queda de potássio no sangue, levando a arritmias cardíacas;
- hipoglicemia, com convulsões e coma em crianças.
Nathália Amorim / ibahia
siga nosso instagram: @plantaohora